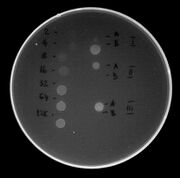

Uploads by MDolinar
From OpenWetWare
Jump to navigationJump to search
This special page shows all uploaded files.
| Date | Name | Thumbnail | Size | Description |
|---|---|---|---|---|
| 09:55, 28 May 2009 | Zivila koncDNA09.jpg (file) |  |
59 KB | Določanje koncentracije izolirane DNA iz sojinega mleka, 2009. |
| 10:02, 26 May 2009 | 09v5s1g2b.jpg (file) |  |
16 KB | vzorci periplazem in celičnih ostankov, 2009 |
| 10:01, 26 May 2009 | 09v5s1g2a.jpg (file) |  |
24 KB | vzorci periplazem in cel. ostankov, 2009 |
| 09:57, 26 May 2009 | Zivila meso09a.jpg (file) |  |
26 KB | sestava mesanega mesa - vaje 2009 / 1,8 % AGE |
| 13:04, 21 May 2009 | 09v5s1g1b.jpg (file) |  |
21 KB | 17,5 % PAGE, 20./21.5.2009 |
| 13:03, 21 May 2009 | 09v5s1g1a.jpg (file) |  |
34 KB | 17,5 % PAGE 20./21.5.2009 |
| 15:06, 13 May 2009 | 09v4s1g3.jpg (file) |  |
47 KB | Analiza 10 transformant - pričakovan vzorec je na progi 8, ki ustreza klonu z oznako 3. |
| 15:38, 11 May 2009 | 09v6s1g2.jpg (file) |  |
86 KB | AGE - analiza VNTR. |
| 15:37, 11 May 2009 | 09v6s1g1.jpg (file) |  |
112 KB | PAGE - analiza STR. |
| 16:29, 4 May 2009 | 09v4s1g2a.jpg (file) |  |
25 KB | 1 % AGE, pET32b po rezanju Eco/Hind, pred izrezom fragmentov (4.5.2009, 1. skupina) |
| 16:22, 4 May 2009 | 09v4s1g2.jpg (file) |  |
28 KB | 2 % AGE pGM1 po rezanju Eco/Hind (4.5.2009) - 1. skupina |
| 16:33, 22 April 2009 | 09v4s1g1.jpg (file) |  |
38 KB | |
| 13:28, 22 April 2009 | 09v3s1g1.jpg (file) |  |
63 KB | 2 ul, 6 ul, netopni ostanek za vektorja pGM1 in pET32 |
| 17:07, 15 April 2009 | 09v1s1g2b.jpg (file) |  |
44 KB | |
| 17:06, 15 April 2009 | 09v1s1g2a.jpg (file) |  |
117 KB | 1 % agarozni gel, naknadno barvanje z EtdBr |
| 15:33, 15 April 2009 | 09v1s1g1.jpg (file) |  |
41 KB | vektorska DNA brez dodatkov levo 1 %, desno 2 % agarozni gel naknadno barvanje z etidijevim bromidom |
| 07:43, 29 May 2008 | V6pon08.jpg (file) |  |
17 KB | Analiza VNTR - ponavljalna vaja 2008. Standard velikosti: lestvica 100 bp. |
| 12:29, 27 May 2008 | V5s1g2b.jpg (file) |  |
21 KB | PAGE periplazemskih frakcij in celičnih ostankov, 1. skupin 2007/8, gel 2 |
| 12:28, 27 May 2008 | V5s1g2a.jpg (file) |  |
46 KB | PAGE periplazemskih frakcij in celičnih ostankov, 1. skupina 2007/8, gel 1 |
| 08:52, 27 May 2008 | Zivila mleko07peroksidaza.jpg (file) |  |
285 KB | peroksidazni test pasterizacije mleka, 2006/7; vzorci kot na sliki fosfataznega testa |
| 08:50, 27 May 2008 | Zivila mleko07fosfataza.jpg (file) |  |
324 KB | fosfatazni test pasterizacije mleka, 2006/7; oznake so: A = alpsko, B = škofjeloško, C = domače nepasterizirano, D = čokoladno, E = kislo mleko |
| 14:14, 23 May 2008 | Zivila soja08a.jpg (file) |  |
33 KB | Produkti PCR pri vaji GS živila (sojino mleko). 2007/8 |
| 09:20, 21 May 2008 | V5s1b-08.jpg (file) |  |
24 KB | Celotni celični lizati pred in po indukciji. 2. gel. Skupina 1, 2007/8. |
| 09:13, 21 May 2008 | V5s1a-08.jpg (file) |  |
24 KB | Celotni celični lizat pred in po indukciji z IPTG. Skupina 1, gel 1, 2007/8. Debelejša lisa pri standardih predstavlja protein z M~25.000. |
| 08:43, 16 May 2008 | Zivila koncDNA08.jpg (file) | |
51 KB | določanje konc. DNA v izolatu iz sojinega mleka; 2007/8 |
| 15:53, 14 May 2008 | V6s1b-08.jpg (file) |  |
63 KB | Analiza VNTR v regiji D1S180, 1. skupina 2007/8 (negativ) |
| 15:44, 14 May 2008 | V4c08.jpg (file) |  |
55 KB | analiza transformant DH5a z lig. produktom: plazmidi po rezanju Eco/Hind; vse skupine 2007/8 |
| 16:41, 12 May 2008 | V6s1-08.jpg (file) |  |
61 KB | vaja forenzika: STR; 2007/8, 1. skupina |
| 09:22, 9 May 2008 | Zivila meso08a.jpg (file) |  |
37 KB | PCR: sestava mešanega mesa, 2008 |
| 07:57, 6 May 2008 | V4s1g1.jpg (file) |  |
47 KB | vaja 4, 1. skupina 2007/8: analiza rezanja z EcoRI |
| 17:14, 5 May 2008 | V4s1g2.jpg (file) |  |
55 KB | preparativna AGE - vektorji po rezanju z EcoRI + HindIII (2008, 1. skupina) negativ |
| 16:24, 21 April 2008 | V3s1g1.jpg (file) |  |
35 KB | 1 % AGE, preparativna izolacija, 1. skupina 2007/8 |
| 15:17, 8 April 2008 | V1S2g2.jpg (file) |  |
73 KB | TrDNA vaje 2007/8; vaja 1 skupina 2; 2. gel: AGE 1 % z EtdBr |
| 09:24, 8 April 2008 | V1S1g2b.jpg (file) |  |
71 KB | Vaje TrDNA 2007/8. Skupina 1 vaja 1 - gel 2 temnejši. |
| 09:23, 8 April 2008 | V1S1g2a.jpg (file) |  |
88 KB | Vaje TrDNA 2007/8; skupina 1, vaja 1 gel 2 (svetlejši). |
| 09:13, 8 April 2008 | V1S1g1.jpg (file) |  |
50 KB | AGE 1. skupina 2007/8 vaja 1 1 % in 2 % gel |
| 10:21, 30 March 2006 | LJU-banner.jpg (file) |  |
211 KB |